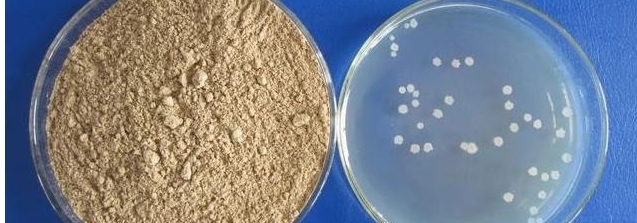

Introductions:
Bacillus subtilis is a species of Bacillus genus. widely distributed in soil and decaying organic matter, and is prone to reproduction in dry grass extracts.It is widely present in nature, non-toxic and harmless, does not pollute the environment.
Product Features
Appearance
brown powder
Odor
slight fermented flavor
Bacillus subtilis
Activity
Water Soluble
Non Water Soluble
( widely using )
( No for Solvent products )
10Billion/g
10Billion/g
20Billion/g
20Billion/g
50Billion/g
50Billion/g
100billion/g
100billion/g
200Billion /g
200Billion /g
Special customized
Special customized
It can be widely used in Agriculture / Animal Feeds / Aquaculture / Environment Protection / The pharmaceutical industry / Others.


Ms Wendy Lee
Mobile&Wechat&Whatsapp : 0086 13562692198
Email :yuedongbiotech@aliyun.com
Ms Jeff Wang
Mobile&Wechat&Whatsapp : 0086 13563622867
Email :wfyuedong@aliyun.com
Ms Sundy Lee
Mobile&Wechat&Whatsapp : 0086 15965090376
Email :yuedongsundy@aliyun.com

